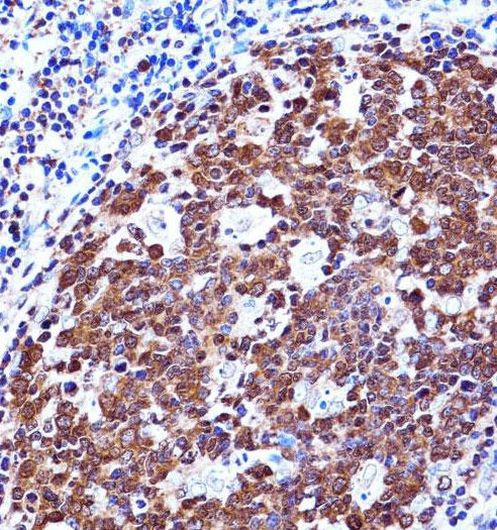
Zap-70 Antibody in Immunohistochemistry (Paraffin) (IHC (P))

Search
Invitrogen
Zap-70 Polyclonal Antibody
{{$productOrderCtrl.translations['antibody.pdp.commerceCard.promotion.promotions']}}
{{$productOrderCtrl.translations['antibody.pdp.commerceCard.promotion.viewpromo']}}
{{$productOrderCtrl.translations['antibody.pdp.commerceCard.promotion.promocode']}}: {{promo.promoCode}} {{promo.promoTitle}} {{promo.promoDescription}}. {{$productOrderCtrl.translations['antibody.pdp.commerceCard.promotion.learnmore']}}
产品信息
PA5-35140
宿主/亚型
分类
类型
抗原
偶联物
形式
浓度
保存条件
运输条件
RRID
靶标信息
ZAP-70 is a cytosolic protein tyrosine kinase that is a member of the Syk family of proteins. ZAP-70 is expressed exclusively in T-cells and natural killer cells and is required for T-cell receptor activation. Upon T cell antigen receptor (TCR) engagement, ZAP70 is phosphorylated on tyrosines 292, 315 and 319 in the interdomain B, located between the SH2 and kinase domains. Phosphorylation of both tyrosines 315 (a Vav binding site) and 319 (a Lck binding site) enhances ZAP70 function in mediating lymphocyte signaling, while tyrosine 292 terminates the transient activation of ZAP70 and attentuates lymphocyte signaling.
仅用于科研。不用于诊断过程。未经明确授权不得转售。